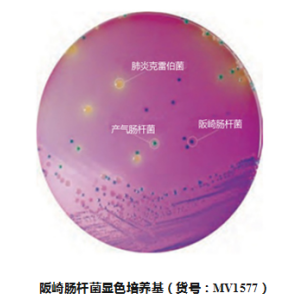
容易“袭击”婴儿的细菌——阪崎肠杆菌

北京缔一生物科技有限公司品牌商
9 年
手机商铺
- NaN
- 0
- 0
- 1
- 0
推荐产品
公司新闻/正文
容易“袭击”婴儿的细菌——阪崎肠杆菌
273 人阅读发布时间:2018-10-08 16:57
新生儿由于免疫功能尚不十分完善,抵御外界疾病的能力十分有限,刚刚脱离母体的婴幼儿,自身不能够主动适应新的环境,一些外界病原微生物很容易击溃婴幼儿脆弱的免疫系统使患儿受到感染。

奶粉是婴幼儿的主要食品,而奶粉中若存在阪崎肠杆菌等细菌可以导致婴幼儿感染、疾病和死亡。阪崎肠杆菌可以对任何年龄段的人群引起疾病,但主要是婴幼儿,特别是1岁以下和出生28天以内的婴儿,早产儿、低体重儿或免疫缺陷的婴幼儿更容易被感染。HIV阳性母亲的婴幼儿更面临双重危险性。因为他们主要依靠奶粉喂养,比其他婴幼儿更容易感染。

来自美国FDA的监测表明,在美国出生体重偏低的新生儿中,感染率为8.7 / 10万;而1岁以下婴儿阪崎肠杆菌感染率为1 / 10万,感染死亡率为 20%至50%。阪崎肠杆菌能引起严重的新生儿脑膜炎、小肠结肠炎和菌血症,并可能引起神经功能紊乱,造成严重的后遗症和死亡,其死亡率高达50%以上。全球从1961年至2003年有案可稽的48起婴儿感染事件中,有25起是新生儿感染。
阪崎肠杆菌自然来源非常广泛,在水、土壤、植物根茎、动物肠道甚至加工食品都可存在,其中婴儿配方奶粉是婴儿感染阪崎肠杆菌的主要渠道。

对于在婴幼儿食品中的阪崎肠杆菌的污染,应该从婴幼儿食品的源头、加工过程以及包装材料等环节控制该菌的污染。
建议
首先我们应该加强婴幼儿食品原料的污染防控,例如,婴幼儿奶粉的原料牛奶,在采购时尽量减少微生物的污染,对原料要进行严格的消毒和检验,对被污染的原料,要及时进行处理,不可进入生产车间,以免对其它原料造成污染。
在加工过程中对各个环节进行严格消毒,如对操作人员的口、手、足、头、鞋、工作服、帽等,都要做好卫生工作。
同时通过加工过程中的巴氏杀菌、超高温杀菌或其他高温工艺彻底的杀灭该菌。要防止阪崎肠杆菌的污染,在生产过程中还应当建立并严格执行行之有效的危害分析和关键控制点质量管理系统。还有要对包装材料进行有效的消毒,生产及包装的整个车间的环境要定期进行消毒。
相关部门对婴幼儿食品原料、成品要进行严格的灭菌和检验,针对婴幼儿食品的安全管理,我国于2010年颁布的《食品安全国家标准婴儿配方食品》GB10765-2010中明确规定,供6个月以下婴儿食用的婴儿配方食品中不得检出阪崎肠杆菌。
我国国家食品安全国家标准中,关于阪崎肠杆菌的检测方法依据GB4789.40—2016,其关键步骤,要有效分离出阪崎肠杆菌,国标中推荐我们使用显色培养基进行分离,这里我们推荐一款好用的,能够有效分离出该菌种的显色培养基。
由威正翔禹|北京缔一生物科技有限公司代理的HiMedia公司(国际知名微生物培养基生产商)生产的阪崎肠杆菌显色培养基(货号:MV1577),该培养基是利用肠杆菌特有的葡萄糖苷酶可特异性裂解显色培养基中的显色底物,呈现蓝绿色菌落。其他微生物不会裂解该显色底物,产生黄色菌落。
其培养基中的混合剂显色,使得阪崎肠杆菌菌落呈现出强烈的的蓝色,而其他肠杆菌的蓝色较浅。可有效的分离出样品中的阪崎肠杆菌,适用用于从食物、牛奶和奶制品中分离鉴定阪崎克罗诺杆菌属(阪崎肠杆菌)。
在35-37℃孵育18-24小时后观察培养特征。
| 菌名(ATCC) |
接种(CFU) |
生长 |
恢复率 |
菌落颜色 |
| 大肠杆菌(25922) |
50-100 |
好-旺盛 |
≥50% |
黄色 |
| 产气肠杆菌(13048) |
50-100 |
好-旺盛 |
≥50% |
绿色 |
| 粪肠球菌(29212) |
≥103 |
抑制 |
0% |
|
| 阪崎克罗诺杆菌(12868) |
50-100 |
好-旺盛 |
≥50% |
蓝色 |
| 金黄色葡萄球菌(25923) |
≥103 |
抑制 |
0% |
|
| 肺炎克雷伯菌(13883) |
50-100 |
好-旺盛 |
≥50% |
绿色(黏液状) |
威正翔禹|缔一生物(Vian-Saga)始终专注于细胞培养,制药,疫苗生产,生物医疗,微生物培养等领域。
我们的使命:为中国生命科学助力
我们的愿景:成为中国专业的生物平台
我们的价值观:成就他人,成就自我。







